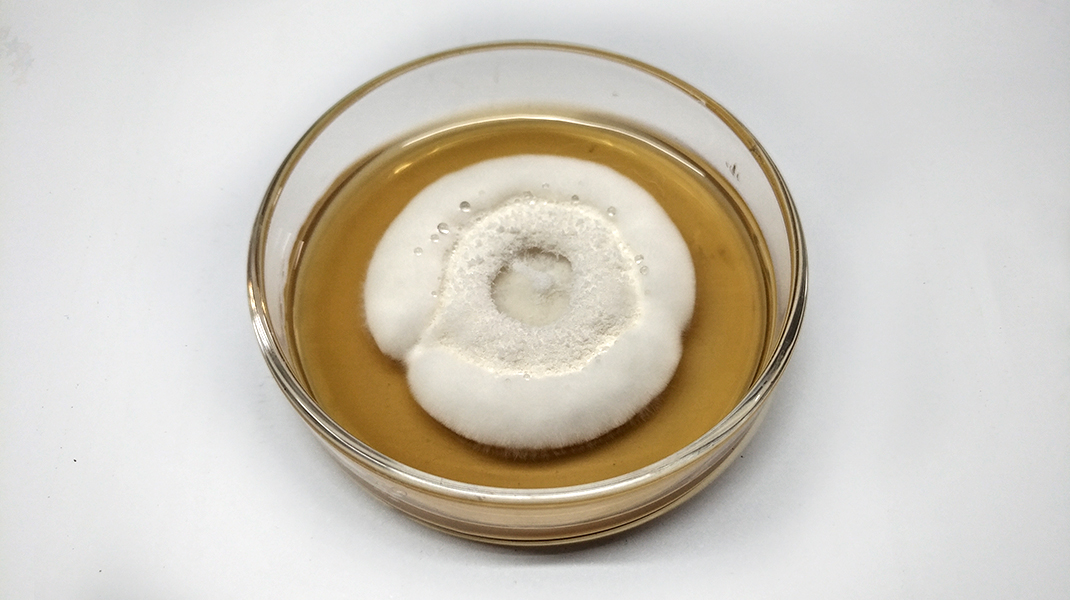
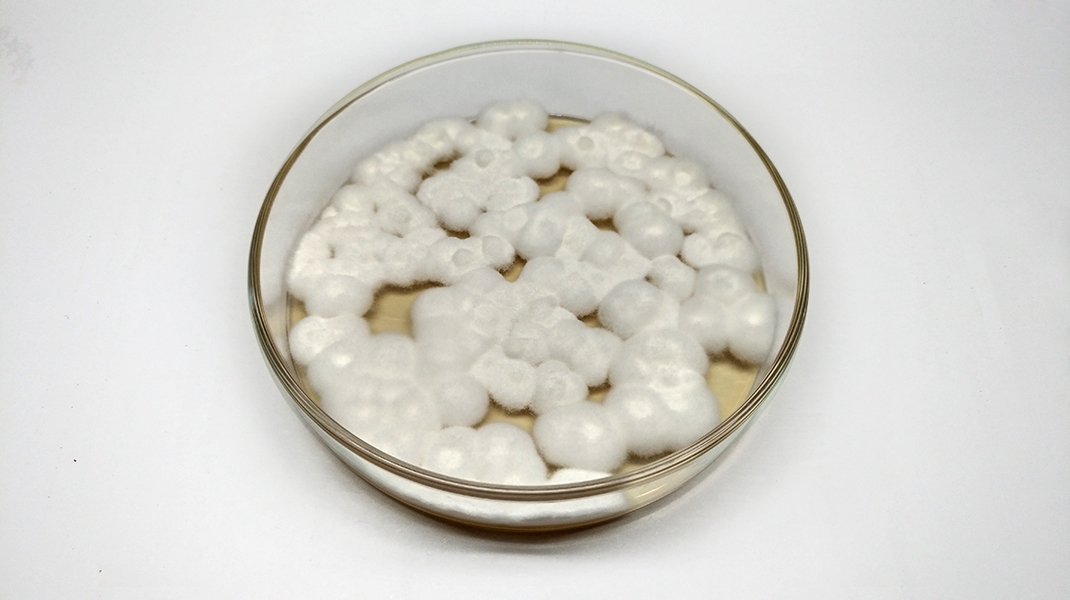

Es común encontrar Beauveria en suelo sobre restos de insectos o bien en insectos que quedan adheridos a las hojas de plantas.
Posee una apariencia algodonosa de color blanco con tonos amarillos. Es de crecimiento lento (entre 10 y 15 días), y puede crecer en un amplio rango de temperaturas con valores de humedad altos (mayor al 60%).
Microscópicamente, Beauveria posee micelio hialino y septado. Una característica distintiva para identificar Beauveria es la forma de sus conidióforos. Éstos poseen forma de jarro (más ancho en el centro que en los extremos) que se extiende en forma de «zig-zag» desde donde emergen los conidios. Los conidióforos suelen ser simples o pueden estar agrupados formando aglomerados.